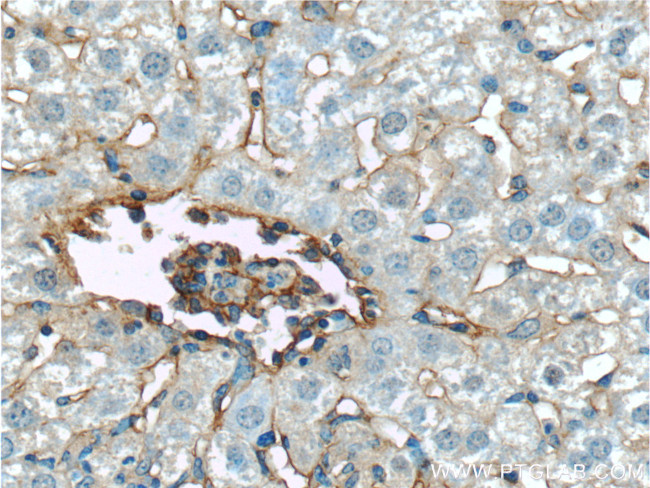
Icam-1 Antibody in Immunohistochemistry (Paraffin) (IHC (P))

Search
Proteintech
Icam-1 Polyclonal Antibody
{{$productOrderCtrl.translations['antibody.pdp.commerceCard.promotion.promotions']}}
{{$productOrderCtrl.translations['antibody.pdp.commerceCard.promotion.viewpromo']}}
{{$productOrderCtrl.translations['antibody.pdp.commerceCard.promotion.promocode']}}: {{promo.promoCode}} {{promo.promoTitle}} {{promo.promoDescription}}. {{$productOrderCtrl.translations['antibody.pdp.commerceCard.promotion.learnmore']}}
产品信息
10020-1-AP
种属反应
已发表种属
宿主/亚型
分类
类型
抗原
偶联物
形式
浓度
规格
纯化类型
保存液
内含物
保存条件
运输条件
产品详细信息
This antibody is raised against mouse Icam-1 which is a cell surface sialoglycoprotein with an apparent molecular weight of 95-100 kDa.
靶标信息
ICAM-1 (CD54) is an 85-110 kDa single-chain type 1 integral membrane glycoprotein with an extracellular domain of five immunoglobulin superfamily repeats, a transmembrane region and a cytoplasmic domain. ICAM-1 has 7 potential N-linked glycosylation sites and shares considerable amino acid sequence homology with ICAM-3 (CD50) and ICAM-2 (CD102). ICAM-1 binds to integrins of type CD11a/CD18 (leukocyte adhesion molecule, LFA-1), or CD11b/CD18 (Mac-1) and is exploited by Rhinovirus as a receptor. ICAM-1 is expressed by activated endothelial cells and detected on epithelial cells, fibroblasts, chondrocytes, B lymphocytes, T lymphocytes (low), monocytes, macrophages, dendritic cells and neutrophils, with lower levels that increase upon inflammation. ICAM-1 is also detected in some carcinoma and melanoma cells. Soluble ICAM-1 is detectable in the plasma and is elevated in patients with various inflammatory syndromes.
仅用于科研。不用于诊断过程。未经明确授权不得转售。
生物信息学
蛋白别名: CD54; Human rhinovirus receptor; ICAM-1; Intercellular adhesion molecule 1; Ly 47; MALA-2; MALA2; MyD10; sCD54; soluble CD54; Surface antigen of activated B cells
基因别名: CD54; ICAM; Icam-1; Icam1; Ly-47; MALA-2
UniProt ID: (Mouse) P13597, (Rat) Q00238
Entrez Gene ID: (Mouse) 15894, (Rat) 25464